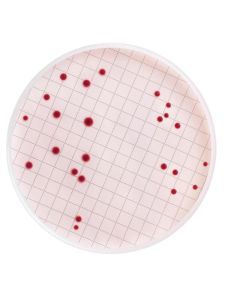
MB000000E.JPG

The store will not work correctly when cookies are disabled.

EXTRATO DE LEVEDURA GRANULADO P/ MICROBIOLOGIA MERCK - 500g
Modelo: 1037530500
R$ 535,18

FRASCO 150mL ESTÉRIL LABORCLIN (EMB C/ 100 UND)
Modelo: LBC572002
R$ 476,79

MSRV MEIO BASE MODIFICADO MERCK - EMB 500G
Modelo: 1098780500
R$ 853,79

PLATE COUNT AGAR (PCA) GRANULADO MERCK - 500g
Modelo: 1054630500
R$ 550,77

DISPOSITIVO ULTRAFILTRACAO AMICON ULTRA-0,5 10KDA MEMBRANA DE CELULOSE REGENERADA (CX C/96) MILLIPORE
Modelo: UFC501096
R$ 3.200,41

MANIFOLD 1 POSIÇÃO EZ-FIT MILLIPORE - P/ TULIPA DE TAMPA DE BORRACHA
Modelo: EZFITH0LD1
R$ 13.203,25

M 17 AGAR SEG. TERZAGHI 500GR MERCK
Modelo: 1151080500
R$ 1.581,06

KIT DE MANUTENÇÃO MANIFOLD EZ-FIT MILLIPORE - INCLUI LUBRIFICANTE E ESCOVA
Modelo: EZFITMAKIT
R$ 1.363,48

CÂMARA UV 366 NM BIVOLT LABORCLIN
Modelo: LBC916004
R$ 2.538,18

MEMB. FILTRAÇÃO MISTURA ESTERES GS DIAM. 13mm PORO 0,22um MILLIPORE (CX/100 UND)
Modelo: GSWP01300
R$ 402,73

M ENDO BROTH DESIDRATADO MILLIPORE EMB C/ 100 GR
Modelo: MB000000E
R$ 1.456,66

DISPOSITIVO ULTRAFILTRACAO AMICON ULTRA-4 10KDA MEMBRANA EM CELULOSE REGENERADA (CX C/24) MILLIPORE
Modelo: UFC801024
R$ 1.434,63